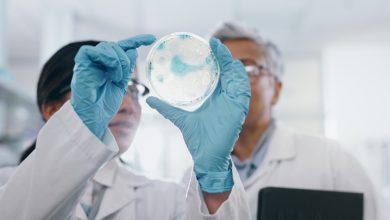

Beauveria bassiana
-
USO E APLICAÇÃO

Iscas com imidacloprido e Beauveria bassiana são alternativa no manejo de praga da cana
Iscas artificiais sólidas tratadas com imidacloprido ou Beauveria bassiana reduziram danos causados por Sphenophorus levis em cana-de-açúcar. O efeito apareceu a partir de 30 dias após…
Leia Mais » -
SUSTENTABILIDADE
Fungo entomopatogênico se destaca como alternativa sustentável no combate a pragas
O controle de pragas na agricultura passa por uma transformação impulsionada pela busca por soluções mais sustentáveis e eficazes. As…
Leia Mais »
